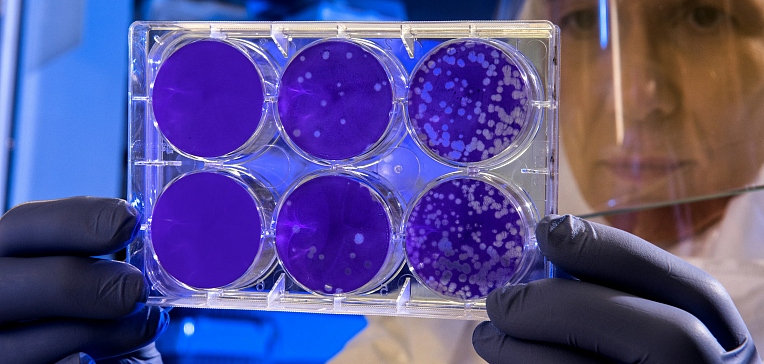

MSCloud. Новый дом для ваших файлов, сегодня и в будущем
Зарегистрируйтесь или войдите сейчас, чтобы загружать, делать резервные копии, управлять и получать доступ к своим файлам на любом устройстве, из любой точки мира, бесплатно.

Разработчики некастодиального криптокошелька TON

Мошенники активизировали распространение вредоносного ПО,

Создатели криптовалютной биржи Garantex, ранее оказавшейся под

Финансовый эксперт и глава инвестиционной компании Maelstrom Артур

Генеральный директор Ripple Брэд Гарлингхаус выразил

Дональд Трамп может представить обновление стратегии Белого

Вчера, 19 марта 2025 года, председатель Федеральной резервной

Xiaomi начала подготовку к запуску смартфонов POCO F7 Pro и POCO

Появилась информация, что на базе сборочной линии «Нижегородских

Белорусский производитель сельскохозяйственной и спецтехники
Совместная группа учёных (Россия и США)

Компания Vivo представила смартфон средне-бюджетного уровня V50

Xiaomi готовится представить смартфон REDMI A5,

Компания Xiaomi объявила о прекращении выпуска обновлений

Компания Xiaomi начала распространение обновления безопасности

Лучший источник света — тот, который есть под рукой. А